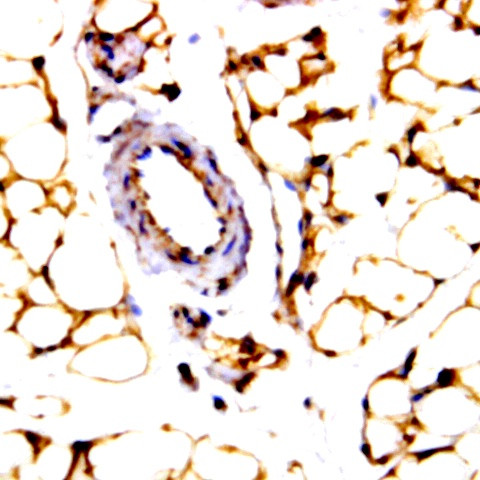
JNK Activating kinase (JKK1) Antibody in Immunohistochemistry (Paraffin) (IHC (P))

Search
AbboMax
JNK Activating kinase (JKK1) Polyclonal Antibody
{{$productOrderCtrl.translations['antibody.pdp.commerceCard.promotion.promotions']}}
{{$productOrderCtrl.translations['antibody.pdp.commerceCard.promotion.viewpromo']}}
{{$productOrderCtrl.translations['antibody.pdp.commerceCard.promotion.promocode']}}: {{promo.promoCode}} {{promo.promoTitle}} {{promo.promoDescription}}. {{$productOrderCtrl.translations['antibody.pdp.commerceCard.promotion.learnmore']}}
图: 1 / 1
JNK Activating kinase (JKK1) Antibody (500-7764) in IHC (P)

产品信息
500-7764
种属反应
宿主/亚型
分类
类型
抗原
偶联物
形式
浓度
纯化类型
保存液
内含物
保存条件
运输条件
产品详细信息
Positive control: Breast carcinoma
靶标信息
MAPK8 (JNK1) is activated by the presence of misfolded proteins in the endoplasmic reticulum. It is also a crucial mediator of insulin resistance and obesity. It belongs to the MAPK superfamily of stress-activated protein kinases. MAPKs are Serine-threonine protein kinases that are activated in response to a variety of extracellular stimuli, and mediate signal transduction from the cell surface to the nucleus. JNK is involved in a wide variety of cellular processes such as proliferation, differentiation, transcription regulation and development. JNK pathways are activated by stress and inflammatory signals. JNK is expressed as ten different isoforms due to differential mRNA splicing. The predominant forms are JNK1 and JNK2.
仅用于科研。不用于诊断过程。未经明确授权不得转售。
篇参考文献 (0)
生物信息学
蛋白别名: c-Jun N-terminal kinase 1; FLJ12099; FLJ33785; JNK-46; JNK1 beta1 protein kinase; JNK3; JNK3A; JUN N-terminal kinase; MAP kinase 10; MAP kinase 8; MAPK 10; MAPK 8; MAPK10; MGC50974; mitogen activated protein kinase 8; Mitogen-activated protein kinase 8; mitogen-activated protein kinase 8 isoform JNK1 alpha1; mitogen-activated protein kinase 8 isoform JNK1 beta2; MK10; OTTHUMP00000019552; p493F12; p54 gamma; p54bSAPK; Phospho-JNK; PRKM10; protein kinase JNK1; protein kinase mitogen-activated 8; SAPK gamma; SAPK1c; stress-activated protein kinase 1; Stress-activated protein kinase 1c; Stress-activated protein kinase JNK1
基因别名: AI849689; JNK; JNK-46; JNK1; JNK1A2; JNK21B1/2; MAPK8; PRKM8; SAPK1; SAPK1C
UniProt ID: (Human) P45983, (Rat) P49185, (Mouse) Q91Y86
Entrez Gene ID: (Human) 5599, (Rat) 116554, (Mouse) 26419